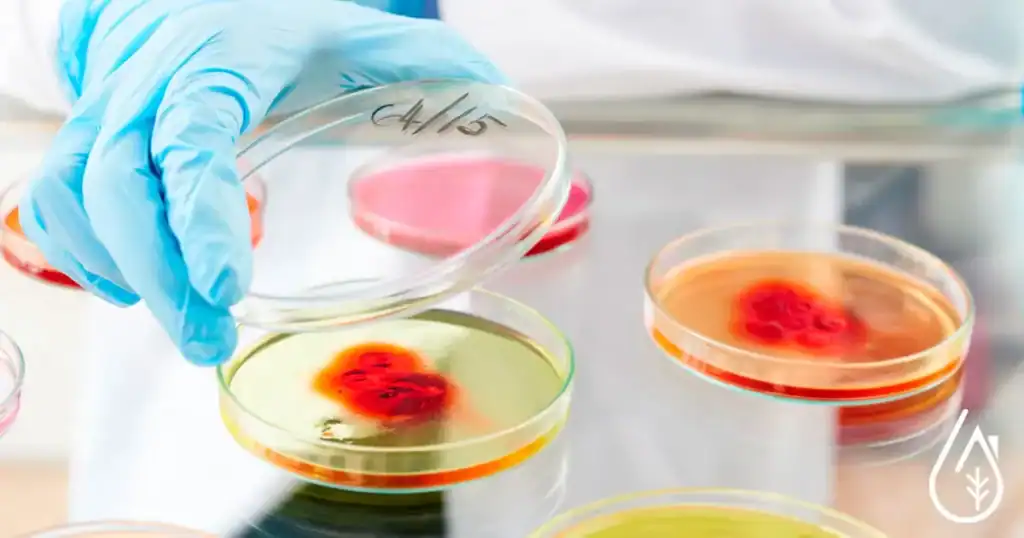
Alvéoles de Petri avec cultures en laboratoire de nettoyage et désinfection.

Blog Diproclean : Parlons ensemble de filtration de l'eau potable
Quelle est l'actualité en 2025 sur la consommation de l'eau potable ?
Vous saurez tout sur les dernières technologies pour une eau saine
7 avril 2025
2 Commentaires
Quel est le cadre légal de la récupération de l’eau de pluie en France ...
Lire la suite
7 avril 2025
2 Commentaires
Fabriquez-vous de la glace contaminée sans le savoir ?
Le rôle significatif de l’eau dans la production de crème glacée L’Impact de la ...
Lire la suite
7 avril 2025
0 Commentaire
Combien coûte vraiment une eau plus pure au robinet ?
Pourquoi filtrer l’eau du robinet Les principaux types de filtres à eau et leur ...
Lire la suite
8 avril 2025
2 Commentaires
Eau potable à bord : les secrets d’une péniche autonome
Les Défis d’accéder à une eau potable saine et pure sur une péniche Évaluation ...
Lire la suite
9 mai 2025
1 Commentaire
Charbon actif vs PFAS : une bataille perdue d’avance ?
Que sont les PFAS et pourquoi sont-ils dangereux ? Quels sont les risques des ...
Lire la suite
17 septembre 2025
0 Commentaire
Eau potable contaminée : comment protéger ta santé en buvant?
Les différentes sources de pollution Les sources de contamination de l’eau Les conséquences de ...
Lire la suite
18 septembre 2025
0 Commentaire
10 choses à savoir absolument en 2025 sur les moustiques.
Il existe des milliers d’espèces de moustiques Seules les femelles piquent C’est l’odeur de ...
Lire la suite
16 octobre 2025
0 Commentaire
10 façons surprenantes d’utiliser la pierre d’argile dans la maison !
Pourquoi tout le monde parle de la pierre d’argile ? Plaques impeccables : dégraissez ...
Lire la suite
23 octobre 2025
3 Commentaires
Guide 2025 Cartouches à eau : comment bien choisir ?
Les cartouches filtrantes anti-sédiments La cartouche anti-calcaire polyphosphate Les cartouches au charbon actif La ...
Lire la suite
4 novembre 2025
5 Commentaires
Prévention araignées hiver : comment protéger votre intérieur efficacement ?
Pourquoi les araignées rentrent-elles dans les maisons en hiver ? Quelles zones de la ...
Lire la suite
9 novembre 2025
1 Commentaire
Éliminer blattes et cafards à la maison : Méthodes efficaces
Comment reconnaître les blattes et les cafards ? Les bons réflexes pour éviter une ...
Lire la suite
19 novembre 2025
1 Commentaire
Les dangers de l’eau du robinet : Comment bien la filtrer ?
Quels contaminants peut-on trouver dans l’eau du robinet ? Pourquoi est-il important de savoir ...
Lire la suite
5 décembre 2025
1 Commentaire
9 envahisseurs silencieux dans votre cuisine – Stoppez-les maintenant !
Poisson d’argent Coléoptères de la farine Coléoptères du pain Charançon de porc Mouches du ...
Lire la suite
15 décembre 2025
0 Commentaire
PFAS dans l’eau : comment filtrer efficacement l’eau de la maison ?
Qu’est-ce que les PFAS ? Quels sont les produits qui contiennent des PFAS dans ...
Lire la suite
31 décembre 2025
1 Commentaire
Osmose inverse de l’eau : fonctionnement réel et performances en 2026
Qu’est-ce que l’osmose inverse ? Comment fonctionne un osmoseur inverse ? Osmoseur classique ou ...
Lire la suite
31 décembre 2025
0 Commentaire
Pesticides dans l’eau du robinet : comment s’en protéger efficacement
Comment savoir si mon eau du robinet est polluée ? Quels sont les risques ...
Lire la suite
1 janvier 2026
1 Commentaire
Eau potable : entre apparence, normes sanitaires et risques invisibles
Que contient réellement l’eau du robinet ? Où trouver les analyses officielles de votre ...
Lire la suite
4 janvier 2026
1 Commentaire
L’eau du robinet est potable… mais pas toujours idéale.
Potable ne veut pas dire pure : ce que contient vraiment l’eau du robinet ...
Lire la suite
5 janvier 2026
0 Commentaire
Que contient l’eau du robinet aujourd’hui ? Analyse complète 2026
Une eau potable conforme… mais que buvons-nous réellement ? Que contient réellement l’eau du ...
Lire la suite
5 janvier 2026
1 Commentaire
Protection des arbres contre les cervidés : méthodes naturelles et efficaces
Poisson d’argent Coléoptères de la farine Coléoptères du pain Charançon de porc Mouches du ...
Lire la suite
6 janvier 2026
1 Commentaire
Filtration de l’eau : la solution idéale existe-t-elle vraiment ?
L’eau potable : principale voie d’exposition Filtration au charbon actif : efficacité et limites ...
Lire la suite
9 janvier 2026
1 Commentaire
Sapin de Noël infesté : mythe ou vraie menace ?
L’eau potable : principale voie d’exposition Filtration au charbon actif : efficacité et limites ...
Lire la suite
9 janvier 2026
0 Commentaire
Eau de pluie : peut-on vraiment la boire sans danger ?
Quelle est l’origine de l’eau de pluie? La collecte de l’eau de pluie Les ...
Lire la suite
9 janvier 2026
0 Commentaire
Que faire des filtres à eau usagés ? Guide complet
Quels sont les différents types de filtres à eau ? Quand changer les filtres ...
Lire la suite
9 janvier 2026
1 Commentaire
Moustiques : comprendre leur invasion estivale pour mieux s’en protéger
Ne pas attirer les moustiques : quelques gestes simples à faire ? 10 conseils ...
Lire la suite
10 janvier 2026
0 Commentaire
Traitement du calcaire au robinet : comparatif des technologies disponibles
Pourquoi votre eau contient du calcaire ? Quels sont les effets du calcaire dans ...
Lire la suite
10 janvier 2026
1 Commentaire
Traitement bactériologique de l’eau potable : méthodes éprouvées et limites
La plupart des bactéries sont tuées par ébullition Recommandations pour les filtres à eau ...
Lire la suite
10 janvier 2026
0 Commentaire
Vos animaux aussi ont le droit à une eau pure !
L’importance de l’eau pour l’équilibre de votre chien ou votre chat. Quelle filtration d’eau ...
Lire la suite
10 janvier 2026
0 Commentaire
Changer le filtre de votre frigo : un geste simple pour une eau plus saine
Pourquoi filtrer l’eau de son réfrigérateur ? Comment fonctionne un filtre à eau pour ...
Lire la suite
12 janvier 2026
0 Commentaire
Punaises de lit : méthodes sérieuses pour une élimination maîtrisée
Comment reconnaître une punaise de lit ? Punaises de lit : quels sont les ...
Lire la suite
12 janvier 2026
0 Commentaire
Pourquoi utiliser l’eau de pluie devient indispensable aujourd’hui ?
Pourquoi récupérer l’eau de pluie devient essentiel aujourd’hui ? Les bienfaits de l’eau de ...
Lire la suite
14 janvier 2026
0 Commentaire
Insectes : stop aux invasions, place aux solutions naturelles
Comment lutter contre les insectes qui envahissent la maison ? Comment protéger les animaux ...
Lire la suite
14 janvier 2026
1 Commentaire
Traitement des nitrates : critères techniques pour un choix fiable et durable
La plupart des bactéries sont tuées par ébullition Recommandations pour les filtres à eau ...
Lire la suite
14 janvier 2026
5 Commentaires
Charbon actif : quelles sont ces propriétés et avantages ?
Qu’est-ce que le charbon actif et pourquoi est-il si utilisé ? Comment fonctionne la ...
Lire la suite
31 mars 2026
0 Commentaire
Quel osmoseur Waterdrop choisir en 2026 ? Notre guide complet
Pourquoi l’osmose inverse Waterdrop attire autant l’attention en 2026 ? Comment fonctionne un osmoseur ...
Lire la suite
Blog Diproclean : l’eau, votre santé et vos solutions
Notre blog explore tous les aspects liés à l’eau : santé, qualité, filtration et innovations. Découvrez des guides pratiques, des comparatifs de filtres, des analyses sur l’eau potable dans le monde et des conseils pour protéger votre famille. Une source fiable pour mieux comprendre, choisir et agir afin de profiter d’une eau saine chaque jour.
Choisissez votre système
Purificateurs d’eau sous évier
Systèmes adaptés à votre besoin journalier en eau potable pour la boisson et la préparation des repas.
Systèmes d’osmose inverse
Modèles d’osmoseurs domestiques selon votre mode vie : sous évier, sur comptoir disponible en eau froide et chaude.
Carafes d’eau filtrée
Choix de capacité et de couleur en fonction de vos préférences pour une garantie d’eau saine au quotidien.
Nos promotions
Idées de cadeaux
Distributeur d’eau chaude osmosée sur comptoir M1 Waterdrop
(0)
Blocs pour rats & souris Diféthialone 25 PPM intérieur/extérieur – boîte 300 g
(0)
Cartouche Charbon Actif à Base Coco Big 20 pouces 115×507 mm
(0)
Étiquettes
analyse eau
animaux domestiques
anti-moustiques
anti-nitrates
boire eau de pluie
cartouches usées
charbon actif
chat
chien
eau contaminée
eau de pluie
eau filtrée
eau filtrée chien
eau osmosée
eau polluée
eau potable
eau potable péniche
eau potable robinet
eau pure
eau pure chat
eau purifiée
eau robinet
filtre charbon actif
filtres saturés
filtre à eau
guêpes
insectes
législation eau de pluie
maison
mouches
osmose inverse
osmoseur domestique
osmoseur Waterdrop
pesticides eau du robinet
Pfas
qualité de l’eau
recycler les cartouches
rendre l'eau potable
réduire Pfas
se débarrasser des moustiques
test bactériologique
traitement bactériologique
traitement nitrates
éliminer les bactéries
éloigner moustiques